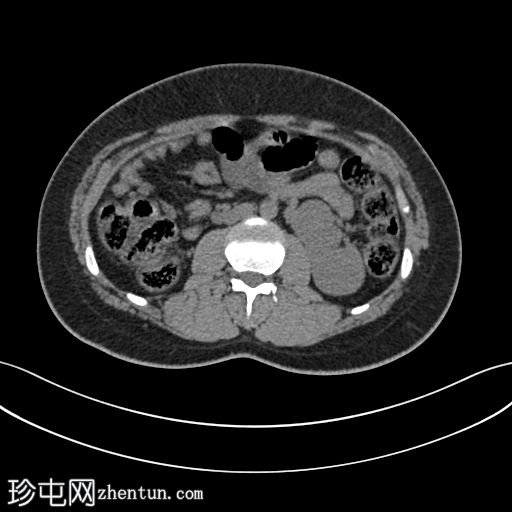
1.jpg
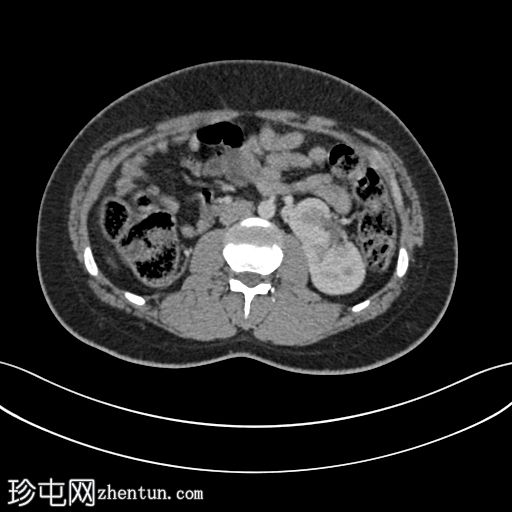
2.jpg
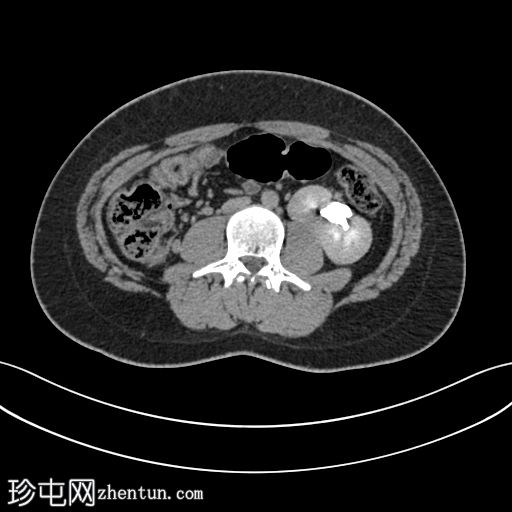
3.jpg

病例介绍
一名患者因非特异性腹痛接受了腹部CT检查。
患者资料
年龄:15岁
性别:男
CT
轴位
平扫
轴位肾皮质期

轴位肾排泄期
斜位肾排泄期
斜位肾排泄期

轴位CT图像显示双肾位于腹部左侧,肾实质融合,符合交叉融合性肾异位。延迟期图像证实双侧输尿管均正常开口于膀胱,右侧输尿管跨越中线开口于右侧膀胱输尿管连接处。
3个病例相关问题
病例讨论
交叉融合性肾异位是一种先天性畸形,指一侧肾脏跨越中线并与对侧肾脏融合。它代表肾融合畸形的一个亚型,是继马蹄肾之后第二常见的类型。其病因被认为与早期胚胎发育过程中肾脏上升和融合异常有关,输尿管芽和后肾胚基的异常迁移促成了这种畸形的发生。
交叉融合肾异位患者通常无症状,该病常在因其他疾病进行影像学检查时偶然发现。当出现症状时,通常与相关并发症有关,例如尿路感染、肾积水或尿路结石。交叉肾的输尿管通常跨越中线,但开口位置与膀胱相同,这是影像学诊断的关键特征。
横断面影像学检查,特别是延迟排泄期CT扫描,有助于确诊、明确解剖结构并评估并发症。由于血管解剖结构和集合系统方向经常出现异常,因此识别这种异常对于适当的临床管理和手术计划至关重要。 |